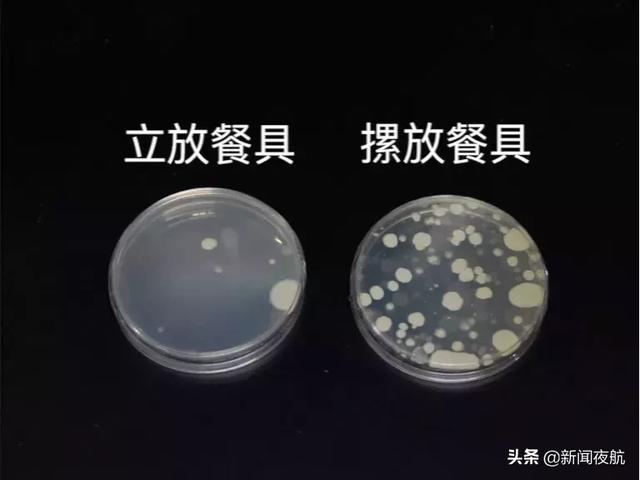
cfu是什么单位，菌落单位CFU读什么（一个实验推翻你多年的习惯）

百科生活 投稿
关于【cfu是什么单位】:菌落单位CFU读什么,今天小编给您分享一下,如果对您有所帮助别忘了关注本站哦。
- 内容导航:
- 1、cfu是什么单位:菌落单位CFU读什么
- 2、碗盘摞着放堪比“二次污染”!注意餐具安全,一个实验推翻你多年的习惯
1、cfu是什么单位:菌落单位CFU读什么
菌落单位CFU就读做:菌落形成单位。菌落形成单位是指在琼脂平板上经过一定温度和时间培养后形成的每一个菌落,是计算细菌或霉菌数目的单位。这个单位比“菌落数”更准确反映问题的实质。
从理论上认识,一个活细菌可以在条件合适的固体表面上形成一个菌落,但实际并非如此。例如,在环境因素作用下,每一个细菌的生活能力各不相同,会影响其在该条件下形成菌落的能力;又如,吸附于微小颗粒上的2个以上菌体或粘连在一起的菌团可能共同形成一个菌落。致使形成的菌落数远远低于实际的活菌数。因此目前可用菌落形成单位代替以往常用的“菌落数”单位。
2、碗盘摞着放堪比“二次污染”!注意餐具安全,一个实验推翻你多年的习惯
洗碗之后,很多人还没等碗盘干透,就习惯性地把它们摞在一起,收入碗柜中。
看似干净利索的好习惯,却会给餐具带来二次污染风险,甚至可能影响身体健康。

图片来源:IC Photo
日前,中国家用电器研究院实验做了一组实验,用数据告诉你餐具摆放如何影响健康。
《生命时报》结合实验并采访专家,教你一套洗碗后的“标准动作”,让你的碗不白洗。
受访专家
中国农业大学食品科学与营养工程副教授 范志红
中国注册营养师 郑飞飞
碗盘摞着放or立着放?
该实验设置了两组进行对比:
实验员先给实验用餐具进行了消毒,并在餐具表面上都涂抹了无菌肉汤。

一组碗盘洗后,直接摞起来放到碗柜中储存;另一组碗盘洗后,立着放于置物架上,并放于通风处。

摞着放于柜中

立着放在物架上
3天后,立着放的餐具细菌数量级为8000cfu/套(cfu是指单位体积中细菌的群落总数),符合我国相关卫生标准,而摞着放的细菌数量是560000cfu/套,为立着放的70倍。
洗完的餐具,放在洗碗机里会如何?
部分洗碗机有消毒的功能,可以在一定程度上减少餐具残留的细菌。但是要注意,很多家庭用完洗碗机,就把餐具留在里面,下顿再接着用。

中国家用电器研究院在实验中,也对从洗碗机中及时拿出,以及在机器中存放了3天、7天的餐具分别进行了检测。

结果发现,只有及时取出的餐具,细菌数量符合国家相关卫生标准,而后两者细菌量分别超标百倍和千倍。
这是因为,洗碗机内部相对密闭且潮湿,非常适宜细菌生长,如将餐具长期放于其中,会导致二次污染。
餐具洗完有个“标准动作”
餐具的正确清洁步骤是:用洗涤剂清洗后,用流动的清水将残留的洗涤剂冲净,再立于镂空置物架上,将餐具沥干;没有水滴后,再将餐具放入橱柜。
类似的,其他餐具,如锅铲、筷子、砧板等,也建议立着放于可沥水的置物架上。
还有些人洗完餐具习惯用抹布擦干,上海市疾病预防控制中心曾在2017年做过一项家庭调查,发现每克餐布的细菌总数高达数十万个,其中包含大肠杆菌、沙门氏菌等致病菌,很可能导致腹泻或消化系统疾病。
所以,尽量不要用抹布擦餐具。如果擦拭,需将抹布先在开水中煮烫,高温消毒后再使用。
5种洗碗法,错上加错
除了上面说的洗完碗盘的摆放,如果在洗碗时无意中犯了这几个错误,不仅会增加洗碗的难度,也会给健康埋下隐患。
饭后把碗摞一起
一些碗十分油腻,有的只盛放了凉菜,如果都把它们摞起来,会使碗的内外都沾上油,增加刷洗工作量。
正确做法:将碗盘分类放,盛粥、装水果凉菜等没有油的碗,应趁着水分没干,立刻冲干净,然后再用洗涤灵清洗油污碗盘。
盘中余油倒进下水道
如果下水道没有安装水油分离装置,油污就是水体最大的污染物。冬天气温低时,还很容易结块,把水管堵上。
正确做法:锅底或盘中有明显余油时,最好直接倒进厨余垃圾桶,或者用厨房纸、吸水纸擦掉。
洗涤剂直接涂碗上
有的人觉得“洗涤剂直接抹在碗上,去油污效果更强”,但这样不仅浪费大量水源,滥用的洗涤剂也会造成水污染。
一旦冲洗不干净,人体摄入洗涤剂后会引发腹泻等肠胃不适。
正确做法:将几滴洗洁剂滴到半碗水中,用洗碗布蘸着稀释后的水来刷碗,冲洗后放在另一个漏篮中,最后再用清水冲干净并控干。
长时间泡着不洗
如果放到下一餐,食物残渣开始发酵,大量微生物滋生,水池里会产生异味,不但给洗碗带来不便,还会带来健康威胁。
正确做法:炒完菜后,趁锅底还有余热时加温水,油污很容易清洗掉。碗筷用热水泡10分钟即可清洗,不宜过长。
洗碗布当“万能布”
一些人家的洗碗布,擦完碗又去擦桌子、灶台,如此反复,污染源扩大,碗盘卫生很难保障。
正确做法:洗碗布应专用,和其他擦拭用布分开,一个月左右更换一次。实在舍不得扔,就把淘汰的洗碗布用来擦窗台和家具。每次洗过碗之后,再用两三滴洗涤剂清洗,彻底晾干,避免微生物繁殖。
来源:生命时报(ID:LT0385)
本文关键词:菌落总数的表示单位cfu是什么意思,菌落单位CFU,菌落单位CFU读什么?,微生物单位cfu怎么读,菌落数cfu怎么读。这就是关于《cfu是什么单位,菌落单位CFU读什么(一个实验推翻你多年的习惯)》的所有内容,希望对您能有所帮助!
- 最近发表